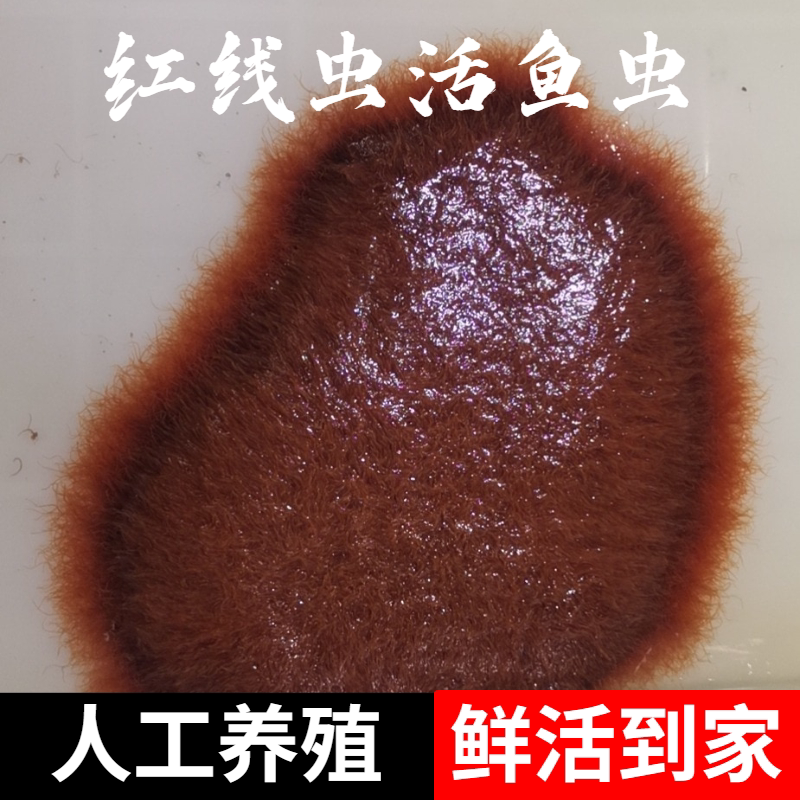
红线虫鱼食活体水蚯蚓丝虫饵料热带观赏鱼开口发色饲料鱼饵

鱼食红线虫

天然鱼食,杀菌冻干处理的红线虫,常温保存不需要冷冻 鱼缸里的大自然
图片尺寸540x960
红线虫活鱼食活体线虫水蚯蚓红丝虫大小观赏鱼高蛋白发色饲料鱼饵
图片尺寸300x300
红线虫鱼食冻干水蚯蚓红丝虫鱼粮孔雀鱼迷你鹦鹉原生斗鱼贴片饲料
图片尺寸800x800
宠宝它 红线虫鱼食线虫活体水蚯蚓丝虫赤血线虫大小观赏鱼发色饲料
图片尺寸800x800
明天尽量发多点#鱼食 #鱼粮 #红线虫 - 抖音
图片尺寸1080x1920
红线虫鱼食活体水蚯蚓丝虫饵料热带观赏鱼开口发色饲料鱼饵
图片尺寸800x800
冷冻红虫鱼食红线虫丰年六角罗汉七彩新鲜优质天然六角恐龙鱼饲料
图片尺寸1128x1128
鱼食,今天买了点鱼食,红线虫.
图片尺寸768x1024
红虫活饵冰冻钓鱼红虫宠物鱼鱼食红线虫鱼食鲜活斑马狗头鱼食迷你
图片尺寸816x816
红线虫鱼食冻干水蚯蚓粘贴片红丝虫燕鱼孔雀灯科斗鱼迷你鹦鹉饲料
图片尺寸750x750
京悠雨冰冻红虫鱼食赤红线虫六角恐龙鱼饵料鱼料丰年虾卵活虫鲜冻高
图片尺寸800x800
红线虫水蚯蚓活鱼食活体线虫红丝虫大小观赏鱼高蛋白发色饲料鱼饵
图片尺寸900x900
冰冻红血虫鱼食冷冻红虫板丰年虾牛心汉堡赤虫红线虫饲料金鱼鱼虫
图片尺寸790x973
红线虫鱼食冻干水蚯蚓粘贴片红丝虫燕鱼孔雀灯科斗鱼迷你鹦鹉饲料
图片尺寸1152x1152
柏馋金鱼饲料红线虫冻干鱼食孔雀鱼燕鱼灯科鱼粮红丝虫粘贴水蚯蚓龟粮
图片尺寸800x800
沃韦朗冻干红线虫贴块鱼食水蚯蚓棉花虫红赤虫鱼粮热带小型鱼饲料
图片尺寸800x800
红线虫活体水蚯蚓丝蚯蚓赤红线虫鱼食活线蛇观赏鱼饲料鱼饵红丝虫
图片尺寸1309x1063
六角恐龙鱼饲料六角恐龙蝾螈专用饲料鲜活虫红线虫活体下沉底栖鱼食
图片尺寸800x800
红线虫鱼食冻干水蚯蚓粘贴片红丝虫燕鱼孔雀灯科斗鱼迷你鹦鹉饲料
图片尺寸800x800
红虫冰冻鱼食牛心汉堡赤红线虫水蚤丰年虾罗汉食七彩神仙饲料
图片尺寸800x800